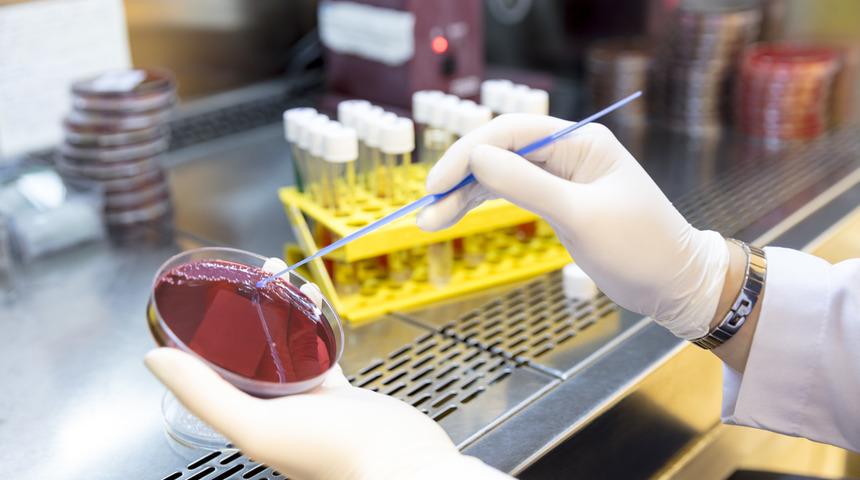
Dünya koronayı konuşuyor ama asıl tehlike kapıda: Bir çizik bile öldürebilir

Aralık 2019’da ortaya çıkan koronavirüs dünya genelinde can almaya devam ederken, uzmanlar insanlığın karşı karşıya kalabileceği daha büyük tehlikelere karşı da dikkat çekiyor.
Avustralya Bilimsel ve Endüstriyel Araştırmalar Organizasyonu’nda (CSIRO) Biyogüvenlik Araştırmaları Direktörü olarak görev yapan Dr. Paul De Barro, koronavirüs salgınını gölgede bırakabilecek tehlikenin ‘antibiyotik direnci’ olduğunu söyledi.
Ada ülkesi Fiji’de üç yıllık bir çalışma yürüten De Barro ve ekibi, yaklaşık 880 binlik nüfusuna rağmen dünyanın en yüksek bakteri enfeksiyonu oranına sahip olan ülkeyi mercek altına aldı. Pasifik adaları ülkelerinde acil durum söz konusu olduğunu belirten De Barro, aşırı antibiyotik kullanımının enfeksiyon hastalıkları riskini artırdığını vurguladı.
CSIRO’nun verilerine göre Fiji’de geçtiğimiz ay 10 kişi leptospiroz hastalığı nedeniyle hayatını kaybetti. Bir bakteri enfeksiyonu olan hastalık hem insanları hem de hayvanları etkiliyor.
Antibiyotik direncinin modern tıbbı karanlık çağlara geri döndürebileceğini söyleyen De Barro, “Eğer Covid’in kötü olduğunu düşünüyorsanız, antibiyotik direncini istemezsiniz. Durumu abarttığımı düşünmüyorum, bu insanlık için en büyük sağlık tehdidi. Covid, antibiyotik direncinin potansiyel etkilerinin yanına bile yaklaşamaz” dedi.
Antibiyotiklerin sağlık sisteminde büyük bir rol oynadığını belirten De Barro, “Basit bir çizik veya doğum yapmak bile sizi öldürebilir. Kanser tedavileri, ameliyatlar, diyabet bunların hepsinin arka planında antibiyotikler kullanılıyor. Eğer yanlış kullanım devam ederse, sağlık sistemi Covid’de gördüğümüz gibi büyük baskı altında kalacak” ifadelerini kullandı.
Koronavirüse karşı en büyük silah olan sosyal mesafenin antibiyotik direncine karşı işe yaramadığını anlatan De Barro, bakterilerin gıdalarda, suda, havada ve günlük temas edilen tüm yüzeylerde bulunduğunu vurguladı. CSIRO'nun çalışmasına göre antibiyotik direnci halihazırda yılda 700 bin ölüme yol açıyor. Eğer önüne geçilmezse bu rakamın dünya genelinde yıllık 10 milyonu bulabileceği öngörülüyor.